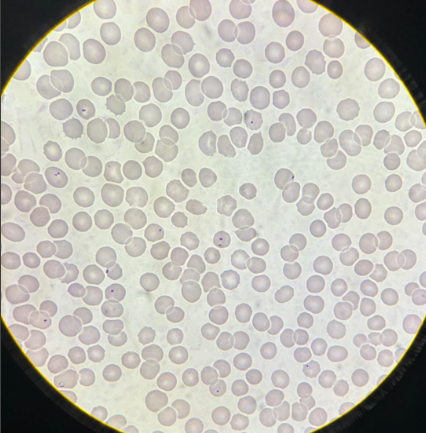
term image
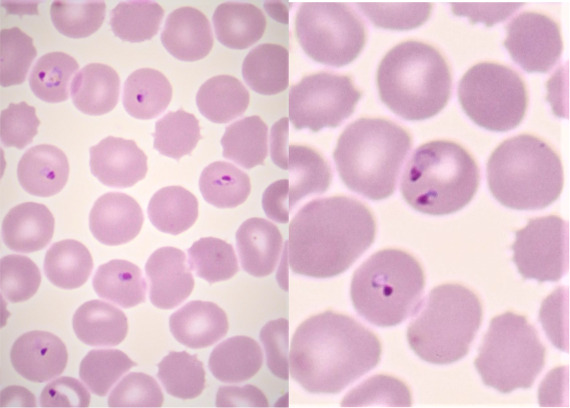
term image
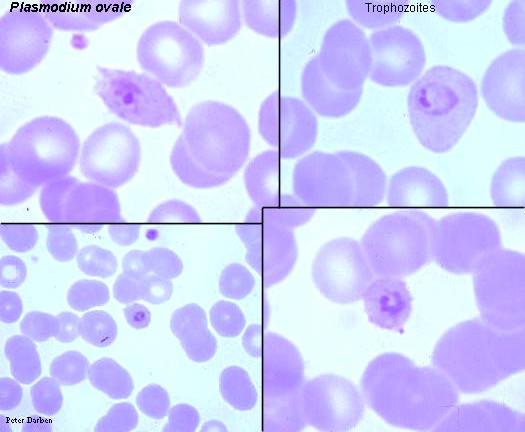
term image

pasożyty praktyka (copy)
1/68
There's no tags or description
Looks like no tags are added yet.
Name | Mastery | Learn | Test | Matching | Spaced |
|---|
No study sessions yet.
69 Terms

wuchnereria bancrofii mikrofilaria

fasciola hepatica postać dojrzała

enterobius vermicularis jaja

trichomonas vaginalis trofozoity

demodex sp imago

trypanosoma cruzi amastigota

cimex lectularius imago

acanthamoeba sp trofozoity

trichuris trichiura jaja

taenia saginata proglotyd przejrzały

ascaris lumbricoides jajo zapłodnione

ascaris lumbricoides jajo niezapłodnione

diphhyllobothrium latum jaja

taenia solium proglotyd przejrzały

taenia sp jaja

schistosoma mansoni jajo

schistosoma mansoni samiec i samica

schistosoma haematobium jajo

schistosoma haematobium jajo

fasciola hepatica/ fasciolopsis buski jajo

paragonimus wersermani postać dojrzała

schistosoma japonicum jajo

fasciolopsis buski jajo

opisthorchis felineus postać dojrzała

paragonimus werstermani jaja

clonorchs sinensis/ opisthorchis felineus jaja

fasciolopsis buski postać dojrzała

entamoeba histolytica trofozoity

trypanosoma cruzi trypomastigota

diphyllobothrium latum proglotydy

naegleria fowleri trofozoity

strongyloides stercoralis larwa

ancylostoma duodenale samica

argas sp postać dojrzała

pulex irritans imago

ixodes ricinus postać dojrzała

cryptosporidium parvum oocysty

loa loa mikrofilaria

toxoplasma gondii trofozoity

toxoplasma gondii trofozoity

trichinella spiralis larwy otorbione

pthirus pubis imago

pediculus sp imago

trichuris trichiura samiec i samica
plasmodium falciparum stadia schizogonii krwinkowej
plasmodium falciparum stadia schizogonii krwinkowej

plasmodium ovale stadia schizogonii krwinkowej
plasmodium ovale stadia schizogonii krwinkowej

babesia sp stadia schizogonii krwinkowej

babesia sp stadia schizogonii krwinkowej

cyclospora cayetanensis oocysty

cyclospora cayetanensis oocysty

leishmania donovani stadia amastigota

leishmania donovani stadia amastigota

giardia intestinalis cysty

hymenolepis nana proglotydy

ancylostoma duodenale samiec

balantidium coli trofozoity

echinococcus granulosus protoskoleksy

enterobius vermicularis samica

entamoeba histolytica cysty

toxoplasma gondii cysty z bradyzoitami

enterobius vermicularis samiec

trypanosoma brucei gambiense trypomastigota

trypanosoma brucei gambiense trypomastigota

sarcoptes scabiei imago

clonorchis sinensis postać dojrzała

giardia intestinalis trofozoity

giardia intestinalis trofozoity